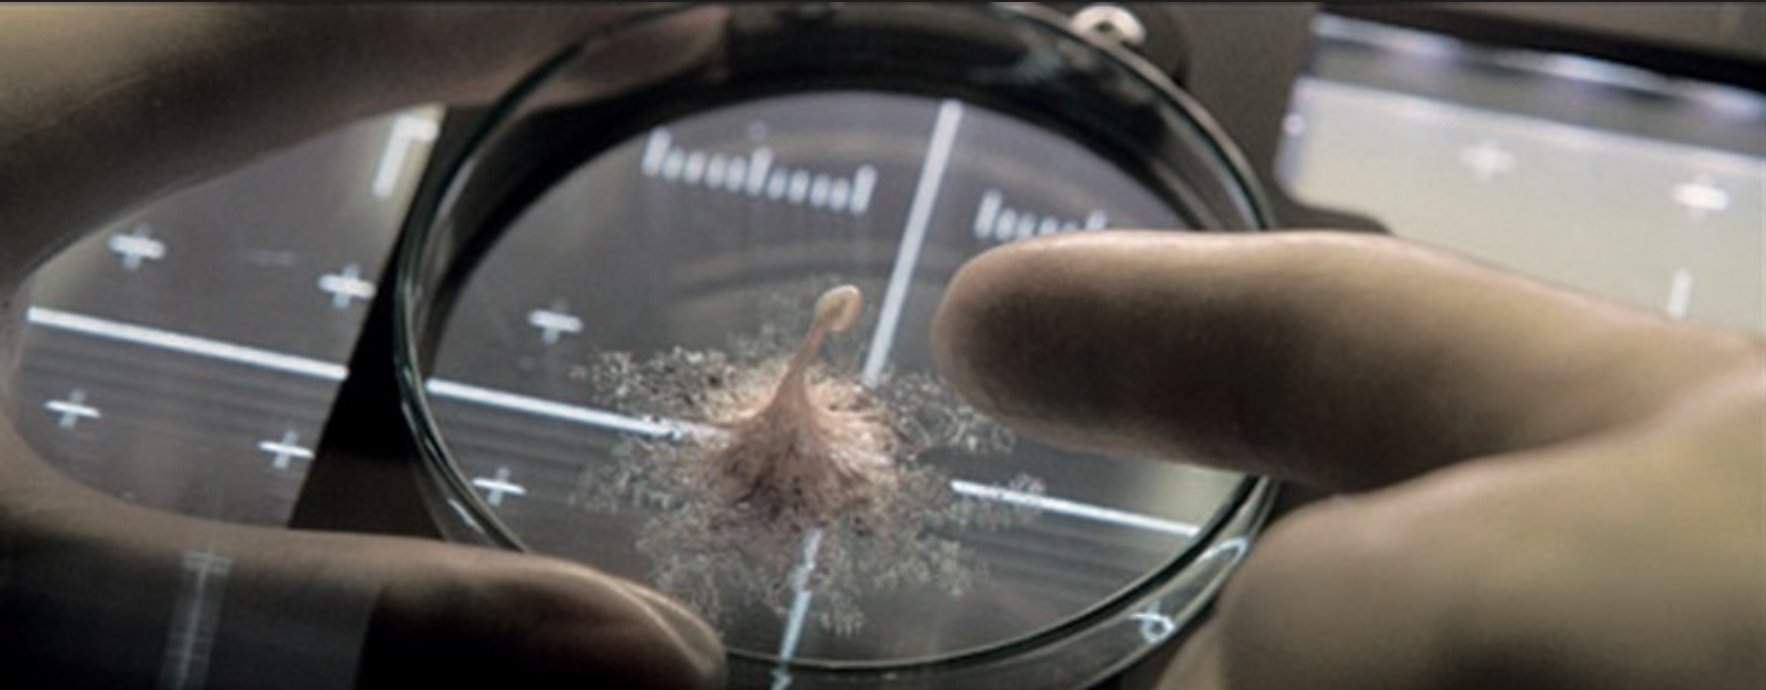

�ۼ� 2023-03-06 14:27:16
�� ��õ
�� ����URL
|
|
|
| https://humoruniv.com/pds1218725 URL ���� |




|


�߱��� 2030�� �ȿ� ���� �ͼ� ���� �м� �Ѵٰ� ��
�ۼ� 2023-03-06 14:27:16
�� ��õ
�� ����URL
|
|
|
| https://humoruniv.com/pds1218725 URL ���� |




|


|
|

2023-03-06
2023-03-06 |
|

|
|
|
|